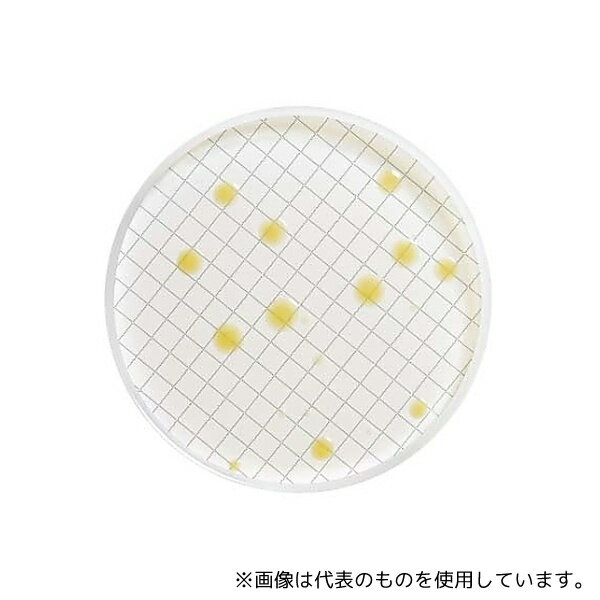
Merck MXSMPCA48 ミリフレックス 標準寒天充填済培地カセット 48×1ST 1箱(48個入)

「花・ガーデン・DIY > DIY・工具」の商品をご紹介します。

【AS ONE】分析・特殊機器|分析機器その他ベクトン・ディッキンソン 252109 BD BBL(TM) ブレインハートインフュージョン寒天培地 20枚
【アズワン AS ONE】分析・特殊機器 分離・分析ロシ 分析機器その他 ●ブレインハートインフュージョン(BHI)寒天培地は臨床、非臨床の各種検体から好気性、嫌気性を問わず多種類の微生物を培養できる培地です 商品の仕様 ●生培地 ●用途:一般細菌用 ●入数:20枚入 ●JANコード:382902521099 【※ご注意ください】商品は代表の画像を使用しています。
5786 円 (税込 / 送料込)

【AS ONE】分析・特殊機器|分析機器その他ベクトン・ディッキンソン 252479 BD BBL(TM) SCD寒天培地 RT 1個(1本×100枚入)
【アズワン AS ONE】分析・特殊機器 分離・分析ロシ 分析機器その他 ●日本薬局方の微生物限度試験など用で、常温保存で6か月の有効期限です。 商品の仕様 ●生培地 ●3局対応 ●入数:100枚入 ●JANコード:382902524793 【※ご注意ください】商品は代表の画像を使用しています。
14630 円 (税込 / 送料込)

【AS ONE】分析・特殊機器|分析機器その他ベクトン・ディッキンソン 252028 BD BBL(TM) LP添加SCD寒天培地 1個(1本×100枚入)
【アズワン AS ONE】分析・特殊機器 分離・分析ロシ 分析機器その他 ●日本薬局方の微生物限度試験など用で、中和剤としてレシチン、ポリソルベートが含有されてます。 商品の仕様 ●生培地 ●3局対応 ●入数:100枚入 ●JANコード:382902520283 【※ご注意ください】商品は代表の画像を使用しています。
23760 円 (税込 / 送料込)

栄研化学 パールコアR ソルビットマッコンキー(SMC)寒天培地 E-MA51 1個
栄研化学 パールコアR ソルビットマッコンキー(SMC)寒天培地 E-MA51 1個●ソルビットの分解能による腸管出血性大腸菌O157と他の大腸菌の分離用●顆粒●内容量:300g
7182 円 (税込 / 送料別)

【AS ONE】分析・特殊機器|分析機器その他栄研化学 E-MR71 ポアメディア?トリプトソイ5%羊血液寒天培地 10枚入
【アズワン AS ONE】分析・特殊機器 分離・分析ロシ 分析機器その他 ●一般細菌及び栄養要求の厳しい菌検査用 5%羊血液添加 商品の仕様 ●生培地 ●内容量:10枚 ●JANコード:4987026223889 【※ご注意ください】商品は代表の画像を使用しています。 【※ご注意ください】0
3036 円 (税込 / 送料別)

【AS ONE】分析・特殊機器|分析機器その他栄研化学 E-MA55 パールコア? 白糖加SSS寒天培地
【アズワン AS ONE】分析・特殊機器 分離・分析ロシ 分析機器その他 ●硫化水素産生性と糖分解能によるサルモネラ及びシゲラの選択分離用(SS寒天培地よりも選択性は弱いがSS-SB寒天培地よりも強い) 商品の仕様 ●顆粒 ●内容量:280g ●JANコード:4987026214672 【※ご注意ください】商品は代表の画像を使用しています。 【※ご注意ください】0
11946 円 (税込 / 送料別)
【AS ONE】分析・特殊機器|培地等Merck MXSMPCA48 ミリフレックス 標準寒天充填済培地カセット 48×1ST 1箱(48個入)
【アズワン AS ONE】分析・特殊機器 培養機器・容器 培地等 ●充填済みミリフレックス専用培地カセットです ●簡単で正確な試験結果が得られます 商品の仕様 ●アプリケーション:水、排水、乳製品(好気性微生物)中の細菌の回収用。 ●テストの種類:Bioburden;Microbial Limits ●テスト数/箱:48 ●ブランド名:Milliflex ●レギュラトリーコンプライアンス:Standard Methods、 United-States Pharmacopeia ●主要アプリケーション:Beer;Bottled Water;Cosmetics;Pharmaceutical Products Analysis;Bioburden Testing;Water Monitoring ●包装:10 mL カンテン プラスチックカセット入り ●品質証明書付き、Y/N:Y ●数量/箱:48 ●概要:ミリフレックスカセット充填済み 標準カンテン培地 ●製品名:充填済ミリフレックス カセット ●製品概要:By combining the Milliflex(R) products、 accessories and services you can immediately streamline your microbial contamination testing workflow、 leverage your quality assurance level by avoiding risks of exogenous contamination and ensure compliance to all GMP/GLP requirements. ●適用できるデバイス:Milliflex ●pH @ 25 ℃:7.0 ± 0.2 ●メディアカラー:明るい琥珀色、透明からわずかに乳発光 ●メディア形態:カンテン ●保存温度、℃:2 から 8; 上向きに置く ●培養時間、h:48?72 ●培養温度、℃:30?35 【※ご注意ください】商品は代表の画像を使用しています。 【※ご注意ください】0
60390 円 (税込 / 送料込)

【AS ONE】分析・特殊機器|分析機器その他島津ダイアグノスティクス 51033 アキュレートサブロー寒天培地 10枚
【アズワン AS ONE】分析・特殊機器 分離・分析ロシ 分析機器その他 ●日本薬局方準拠培地 ●真菌用 商品の仕様 ●入数:10枚 ●重量:400g ●※保存方法:4~10℃(凍結不可) ●有効期限:製造後6ヶ月 ●★1枚あたりのサイズ:蓋φ89.5×全高14.5mm ●JANコード:4987302510337 【※ご注意ください】商品は代表の画像を使用しています。
1947 円 (税込 / 送料別)

【AS ONE】分析・特殊機器|分析機器その他ベクトン・ディッキンソン 251507 BD ロダック(TM) プレート デソキシコレート寒天培地 1個(1本×30枚入)
【アズワン AS ONE】分析・特殊機器 分離・分析ロシ 分析機器その他 ●食品製造環境及び調理、従事者向けのスタンプ式の培地です。 商品の仕様 ●生培地 ●コンタクトプレート ●入数:30枚入 ●JANコード:382902515074 【※ご注意ください】商品は代表の画像を使用しています。
4972 円 (税込 / 送料込)

【AS ONE】分析・特殊機器|分析機器その他ベクトン・ディッキンソン 251600 BD BBL(TM) コロンビアCNA5%ヒツジ血液寒天培地/マッコンキーII寒天培地 20枚
【アズワン AS ONE】分析・特殊機器 分離・分析ロシ 分析機器その他 ●本培地は、1枚で2種類の培地が併用できる様に組合わされた便利で効率の良い培地で、発育性にすぐれたグラム陽性球菌の選択培地であるコロンビアCNA5%ヒツジ血液寒天培地とグラム陰性桿菌の選択分離にすぐれたマッコンキーII 寒天培地の組合わせです 商品の仕様 ●生培地(分画培地) ●入数:20枚入 ●JANコード:382902516002 【※ご注意ください】商品は代表の画像を使用しています。
7469 円 (税込 / 送料込)

【送料無料】栄研化学 粉末培地(ボトル顆粒) パールコア 標準寒天 E-MB65 1個
メーカー 栄研化学 商品カテゴリ 実験用器具・消耗品>実験用消耗品 発送目安 1日~2日以内に発送予定(土日祝除) お支払方法 銀行振込・クレジットカード 送料 送料無料 特記事項 その他
8049 円 (税込 / 送料込)

【AS ONE】分析・特殊機器|微生物検査用品島津ダイアグノスティクス 5204 アキュディア? TCBS寒天培地(粉末) 300g
【アズワン AS ONE】分析・特殊機器 検査用品 微生物検査用品 商品の仕様 ●腸炎ビブリオ・コレラ菌選択分離用 ●内容量:1本(300g入) ●保存方法:室温・防湿 ●JANコード:4987302052042 【※ご注意ください】商品は代表の画像を使用しています。 【※ご注意ください】0
6534 円 (税込 / 送料別)

【AS ONE】分析・特殊機器|分析機器その他●ベクトン・ディッキンソン 251275 BD BBL(TM) ミューラーヒントンII寒天培地 100枚
【アズワン AS ONE】分析・特殊機器 分離・分析ロシ 分析機器その他 ●ミューラーヒントンII 寒天培地は、Kirby-Bauer 法に基く薬剤感受性テスト用培地で、CLSI M2-A9 により推奨されています 商品の仕様 ●生培地 ●用途:薬剤感受性テスト用 ●入数:100枚入 ●JANコード:382902512752 【※ご注意ください】商品は代表の画像を使用しています。 【※ご注意ください】0
26290 円 (税込 / 送料込)

【AS ONE】分析・特殊機器|分析機器その他ベクトン・ディッキンソン 251549 BD ロダック(TM) プレート CP添加ポテト寒天培地 1個(1本×30枚入)
【アズワン AS ONE】分析・特殊機器 分離・分析ロシ 分析機器その他 ●食品製造環境及び調理、従事者向けのスタンプ式の培地です。 商品の仕様 ●生培地 ●用途:食品検査用 ●入数:30枚入 ●JANコード:382902515494 【※ご注意ください】商品は代表の画像を使用しています。 【※ご注意ください】0
6963 円 (税込 / 送料別)

【AS ONE】分析・特殊機器|分析機器その他極東製薬工業 2230 極東 TSI寒天培地 300g
【アズワン AS ONE】分析・特殊機器 分離・分析ロシ 分析機器その他 ●腸内細菌確認用培地 ●性状確認用 商品の仕様 ●粉末 ●JANコード:4987551022308 【※ご注意ください】商品は代表の画像を使用しています。 【※ご注意ください】0
7084 円 (税込 / 送料別)

【AS ONE】分析・特殊機器|分析機器その他栄研化学 E-MB07 粉末培地(ボトル) CVT寒天培地
【アズワン AS ONE】分析・特殊機器 分離・分析ロシ 分析機器その他 ●低音細菌検査用 商品の仕様 ●粉末 ●内容量:100g ●貯蔵方法:室温保存 ●JANコード:4987026259536 【※ご注意ください】商品は代表の画像を使用しています。 【※ご注意ください】0
7271 円 (税込 / 送料別)

【送料無料】極東製薬工業(Kyokutoseiyaku) 細菌検出用培地 DDチェッカー (DD寒天) 04200 1ケース(20枚×2箱入)
メーカー 極東製薬工業(Kyokutoseiyaku) 商品カテゴリ 実験用器具・消耗品>実験用消耗品 発送目安 1日~2日以内に発送予定(土日祝除) お支払方法 銀行振込・クレジットカード 送料 送料無料 特記事項 その他
7038 円 (税込 / 送料込)

【AS ONE】分析・特殊機器|分析機器その他栄研化学 E-MD03 粉末培地(ボトル顆粒) パールコア(R) TCBS寒天培地
【アズワン AS ONE】分析・特殊機器 分離・分析ロシ 分析機器その他 ●コレラ菌・腸炎ビブリオ分離用 商品の仕様 ●顆粒 ●内容量:300g ●JANコード:4987026099101 【※ご注意ください】商品は代表の画像を使用しています。
7788 円 (税込 / 送料込)

【AS ONE】分析・特殊機器|分析機器その他栄研化学 E-MP37 生培地 ポアメディア TCBS寒天 1パック(10枚入)
【アズワン AS ONE】分析・特殊機器 分離・分析ロシ 分析機器その他 ●コレラ菌・腸炎ビブリオ分離用 商品の仕様 ●生培地 ●内容量:10枚 ●JANコード:4987026267289 【※ご注意ください】商品は代表の画像を使用しています。
2090 円 (税込 / 送料別)

【AS ONE】分析・特殊機器|培地等栄研化学 PK0010 ぺたんチェックII25 SCDLP寒天培地 1箱(10枚×4袋入)
【アズワン AS ONE】分析・特殊機器 培養機器・容器 培地等 ●器具・培地調整等の事前準備が不要で、1人で容易に操作できます。 ●汚染実態の把握・消毒殺菌効果判定が肉眼ででき、また汚染源の特定菌の有無を判定することができます。 ●培地を凸状に盛り上げた、コンタクト(接触)平板です。 商品の仕様 ●使用目的:一般生菌数測定用 ●培地色調:淡黄 ●測定する集落:発育したすべての集落 ●入数:1箱(10枚/袋×4袋入) ●培地表面積:約25cm2 ●※保存方法2~10℃(遮光・凍結不可) ●※有効期限:製造より6ヶ月 ●JANコード:4987026353487 【※ご注意ください】商品は代表の画像を使用しています。
10230 円 (税込 / 送料込)
![アズワン AS ONE 粉末培地ポテトデキストロス寒天10130 6-8814-04 [1445-0018398]](https://thumbnail.image.rakuten.co.jp/@0_mall/daishinshop/cabinet/item/1445-13/1445-0018398.jpg?_ex=128x128)
画像は代表画像です!ご購入時は商品説明等ご確認ください!アズワン AS ONE 粉末培地ポテトデキストロス寒天10130 6-8814-04 [1445-0018398]
納期目安 (メーカーに在庫がある場合)13:30までにご注文の場合約3~7日後出荷(土日祝日を除く)※表示の納期目安はあくまで目安ですのでお約束ではありません。具体的納期は都度お問い合わせください。お取り寄せ品です!ご注文後[商品欠品]及び[商品完売(廃番)]が発生する場合がございます。あらかじめご了承の上ご注文お願いいたします!またご注文の数量、お届け先によって別途送料が発生する場合がございます。その場合当店よりご連絡させていただきますのでご対応お願いいたします。商品未発送の状況でもメーカーによってはキャンセル不可となり場合もございますのでご了承の上ご注文お願いいたします。※記載の商品画像はイメージ(代表)画像ですので画像だけの情報のみでご購入はお控え頂き、必ず記載内容をご確認下さい。・本製品は研究者・事業者向け商品です。家庭用・一般用商品ではありません。・仕様・型番:10130・培地名:ポテトデキストロース寒天・適合:酵母及びカビの分離・培養及び菌数測定・容量:500g・※保存方法:15~30度当社管理番号6-8814-04--検索キーワード--
17952 円 (税込 / 送料別)

【送料無料】日水製薬 アキュディア? R2A寒天培地(顆粒)「ニッスイ」 300g 05515 1本
メーカー 日水製薬 商品カテゴリ 実験用器具・消耗品>実験用消耗品 発送目安 1日~2日以内に発送予定(土日祝除) お支払方法 銀行振込・クレジットカード 送料 送料無料 特記事項 その他 [島津ダイアグノスティクス]
9375 円 (税込 / 送料込)

【AS ONE】分析・特殊機器|分析機器その他栄研化学 E-MR93 ポアメディア?羊血液寒天培地M58 10枚入
【アズワン AS ONE】分析・特殊機器 分離・分析ロシ 分析機器その他 ●一般細菌及び栄養要求の厳しい菌検査用 5%羊血液添加(特にA群溶血レンサ球菌のβ溶血環が鮮明) 商品の仕様 ●生培地 ●内容量:10枚 ●JANコード:4987026156200 【※ご注意ください】商品は代表の画像を使用しています。 【※ご注意ください】0
3036 円 (税込 / 送料別)

【AS ONE】分析・特殊機器|分析機器その他栄研化学 E-MR70 生培地 ポアメディア WYOα寒天 1パック(10枚入)
【アズワン AS ONE】分析・特殊機器 分離・分析ロシ 分析機器その他 ●レジオネラ属菌の選択分離用 商品の仕様 ●生培地 ●内容量:10枚 ●JANコード:4987026170800 【※ご注意ください】商品は代表の画像を使用しています。
5489 円 (税込 / 送料込)

【AS ONE】分析・特殊機器|分析機器その他ベクトン・ディッキンソン 252959 BD BBL(TM) CHROMagar(TM) カンジダII寒天培地 100枚
【アズワン AS ONE】分析・特殊機器 分離・分析ロシ 分析機器その他 ●BD BBL(TM) CHROMagar(TM) カンジタ寒天培地はC. albicans、C. tropicalis、C. krusei の分離区別のために用いられます。 ●また、他の酵母様真菌や糸状様真菌の分離においてもサブローデキストロース寒天培地または同様の培地の代わりとして用いることかできます 商品の仕様 ●生培地 ●用途:真菌、イースト、カビ用 ●入数:100枚入 ●JANコード:382902529590 【※ご注意ください】商品は代表の画像を使用しています。
30030 円 (税込 / 送料込)

栄研化学 パールコアR ハートインフュジョン寒天培地 E-MC85 1個
栄研化学 パールコアR ハートインフュジョン寒天培地 E-MC85 1個●一般細菌及び栄養要求の厳しい菌の培養及び分離用●顆粒●内容量:300g
11927 円 (税込 / 送料別)

【AS ONE】分析・特殊機器|分析機器その他島津ダイアグノスティクス 50032 アキュレート?トリプトソーヤ寒天培地 100枚
【アズワン AS ONE】分析・特殊機器 分離・分析ロシ 分析機器その他 ●日本薬局方準拠培地 ●一般細菌用 商品の仕様 ●入数:100枚 ●重量:4000g ●※保存方法:4~10℃(凍結不可) ●有効期限:製造後6ヶ月 ●★1枚あたりのサイズ:蓋φ89.5×全高14.5mm ●JANコード:4987302500321 【※ご注意ください】商品は代表の画像を使用しています。
13750 円 (税込 / 送料込)

【AS ONE】分析・特殊機器|分析機器その他島津ダイアグノスティクス 51059 アキュレートGVPC寒天培地 10枚
【アズワン AS ONE】分析・特殊機器 分離・分析ロシ 分析機器その他 ●本培地は、環境水からLegionella属菌を分離するための選択分離培地である。 ●夾雑菌の多い環境水からの分離検査に適している。 ●非選択分離培地であるBCYEα寒天培地を基礎培地とし、グリシン、バンコマイシン、ポリミキシンBおよびシクロヘキシミドが選択剤として添加されている。 ●環境水中に夾雑菌が多く存在すると、非選択分離培地である BCYEα 寒天培地は役立たない場合が多く、選択分離培地を複数枚併用することで良い結果が得られやすい。 ●しかし、選択分離培地の抗菌剤がLegionella属菌の発育に影響するするため、非選択分離培地であるBCYEα寒天培地を併用すべきであるといわれている。 ●「ISO11731:1998(E)」や「新版レジオネラ症防止指針」に掲載された培地と同組成の培地である。 商品の仕様 ●包装:10枚 ●貯蔵方法:冷暗所(4~10℃)保存禁凍結 ●サイズ:W10cm×H15cm×D10cm ●JANコード:4987302510597 【※ご注意ください】商品は代表の画像を使用しています。
4796 円 (税込 / 送料込)


